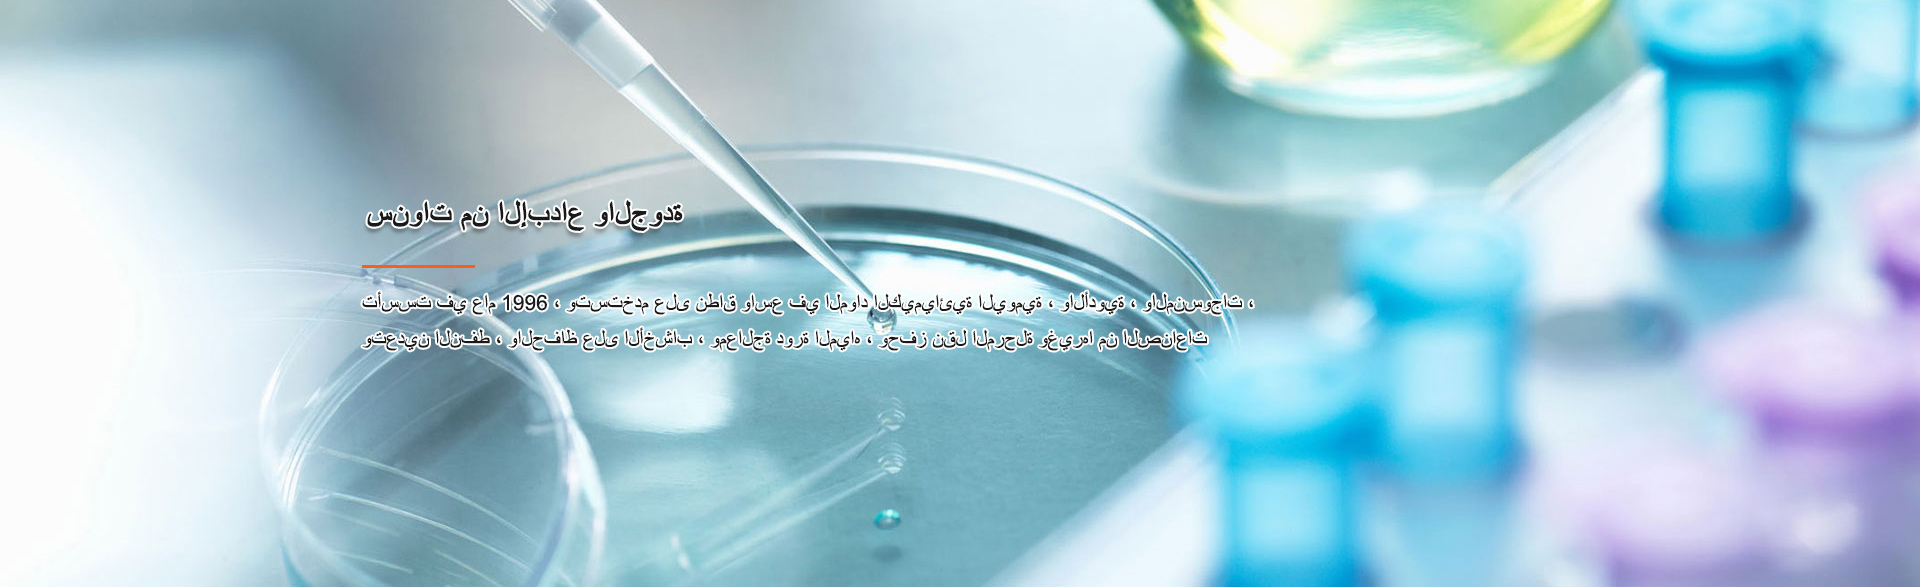

鵬辰新材料科技股份有限公司
Pengchen New Materials Technology Co., Ltd.

????? ??????

????????? ?? ?????

???? ?????? ????????

?????? ??????
???? ????????
???? ?????? ???? ????? ?? ????? ???? ????? S ?? ???????? ?????????????? ??????? ????? ??????? ??????? ?????? ? ???????? ??????? ????? ??????? ? ????????? ? ????? ??????? ? 1-????? ??????? ? 2-????? ??????? ? ??????? ? ???.

????????
???????? ??????? ?????? ???
???????? ??????? ????? ??????? ??? ???? ???? ???? ???? ???? ?? ???????? ???????? ?????????? ? ??? ???? ?????? ??????? ????????? ?????? ? ???? ????? ?????? ??????? ?????? ? ??????? ???????? ? ???????? ???????? ? ???????? ?????????? ??????????? ???????? ? ???.


?????? ???????
?????? ????????
?????? ???? ????? ????? ???? ????? ?????? ? ??????? ??? ??????? ? ??????? ????? ? ????? ????????? ????? ???????? ??????? ?? ???? ???? ?????.


????? ?????????? / ?????? ?????????? ?????

??? ???
Peng Chen New Materials Technology Co., Ltd.(Wujiang Wanshida Solvent Co., Ltd.) ???? ?????? ?? ????? ????? ??????? ??????? ????? ????? ???? ???? ??? ? ???? ?? ???? 318 99.6 ???????? ???? ???? ???? ??????? ?????? 頔 ????? ??? ???? ????? ???? ? ??????? ????????? ?????? ? ?????? ???????.
??? ???? ?????? ??????? ????? ??????????? ????????? ????? ????? ???????? ??????? ? ?????? ??????? ?????? ?? ??????? ??????? ? ???? ???? ?????? ?????? ????? ?? ??????? ????????? ? ?? ?????? ?? ???? ????? ???????? ???? ????? ? ??? ??? ISO9001 ???? ????? ?????? ?????? ISO14001 ???? ??????? ??????? ? OHSAS18001 ????? ??????? ?????? ??????? ????? ???? ? ????????? ?? ??????? ?????? ??????? ???????? .
???? ???? ????? ?? ???? S ????? ????? ?????? ?????? ???? ??????? ???????? ??????? ? ??????? ???? ??????? ??????? ???????? ? Durene ? PMDA ? ????? ????????? ????????? ? 1 - 2 - ??????? ????? ????????? ????????? ???????? ?????? ?? ???????? ? ???????? ?????????. ???????? ????????? ??? ???? ???? ?? ??????? ???? ??????? ? ???????? ? ?????? ??????? ???????? ?????????? ? ?????? ???????? ???????? ?????? ?? ????????.
????? ???????? ??? ???????? ?????? ?????? ? ?????? ?? ?????? ?????? ? ???? ?????? ???? ?????? ???? ??? ???? ??????? ??????? ????????? ???????? ????????.

???????
???? ??????? ?? ??????? ?? ?????? ??????? ???????? ??????? ?? ??????? ?????????? ??????? ?????? ???? ????? ???? ????

?? ???? ????? ????? ? ????????? ????? ??????? ?????? ? ??????? ?????? ?????? ?? ??? ???????

??????? ??? ?????? ? ?????? ??????? ??????? ????? ?????? ?? ???? ?????? ?????? ??? ???? ????

???? ???? ???? ????? ??? ???? ??????? ??????? ???????

?????? ?????????? ??????? ??? ????? ? ?? ?????????
4 ????? ?????????
????? ???? ????? ?? ????? ???? ????? S ?? ???????? ??????? ????? ??????? ??????? ?????? ? ???????? ??????? ????? ??????? ? mesitylene ? methylnaphthalene ? 1-methylnaphthalene ? 2-methylnaphthalene ? naphthalene ? ???.
??? ??????? ????????
????? ?? ??????? ????? ?????? ???????


????? ???? ????? ?? ????? ???? ????? S ?? ???????? ??????? ????? ??????? ??????? ?????? ? ???????? ??????? ????? ??????? ? mesitylene ? methylnaphthalene ? 1-methylnaphthalene ? 2-methylnaphthalene ? naphthalene ? ???.
????? ?????????
??????? ?????? ?? ??????? ????????? ????????


???? ?????? ??????? ???? ?????? ?????????? ?????? ?????? ? ???? ????? ???? ? ?????? ??????? ????? ? ???? ?????? ????? ? ?????? ???? ?????? ?????? ??? ?????? ??????? ????????? ???????.
???? ??????
??????? ?????? ?????? ? ???? ???? ?????? ???????


????? ?????? ?????? ??????? ???????? ?? ????? ?????? ????? ? ?????? ?????? ???? ?????? ????? ??????? ??????? ? ??????? ????? ???? ????? ?????? ISO9001 ? ?????? ???? ????? ?????? ISO14001 ?????? ???? ????? ????? ???????? ??????? OHSAS18001 ? ??????? ????? ??????? ???? ??????? ???????
???? ??????
???? ?? ??? ????? ????? ?? ?????


???????? ??? ?? ???? ?? 20 ????? ?? ?????? ?? ??????? ? ???? ?????? ????? ?? ???????? ???? ???? ???????? ??????? ????????? ?? ???? ????? ???????? ??????? ? ????? ????? ????? ???? ????? ?????? ????? ?????? ??????. ????? ?????? ????????? ???? ????? ??? ?????? ???????? ?????? ??? ?????? ???????? ?????? ?? ?????? ???????? ????????.
???????
??????? ??? ?????? ??????? ???????
27
[ 2018-09 ]
????? ????? ?????? ????? ????? ??????? ?
????? ???????? ??????? ?????? ?? ???? ??????? ??? ??????? ?? ???????? ???? ????? ?????? ????????? ???????? ?????...
03
[ 2017-11 ]
CHINACOAT2017 | Pengchen New Materials ?
2017-11-03 ???? Pengchen ??????? ????? ???? ????? ?????? ?????? (CHINACOAT 2017) ?? 15-17 ?????? ?? ???? ?????? ?????? ...
25
[ 2017-02 ]
???? ?? ???? ?????????? ???????? 2017
CAC2017 ???? ???? ????? ?????? ?????? ??? ?????????? ???????? ?????? ?????? 3.1-3 ???? (???????? ??? ??????) ?? ???? ???...
17
[ 2017-02 ]
??? ??? ??? ???????
?? ???? ??? 12 ?????? ? ?? ??? ????? ?????? Xuwei ?????? ??????? ??????? ?????? Pengchen 500000 ?? / ??? ??? ??? ???????...
???????: ????? ????? ??????? ??????? ????? ????? ???? ???? ??? ?? ( ???? 318 99.6 ????????)
??????: +86-512-63680537 ( ?????? ) ??????: +86-512-63688189 ?????? : +86-13812979999 ?????? : +86-13375160921
E-mail: pc@pengchenchem.com, mayon@pengchenchem.com
URL: www.pengchenchem.com
Copyright(C)2020, Pengchen New Materials Technology Co., Ltd. All Rights Reserved. Supported by ChinaChemNet ChemNet Toocle Copyright Notice 備案序號:蘇ICP備17008233號
